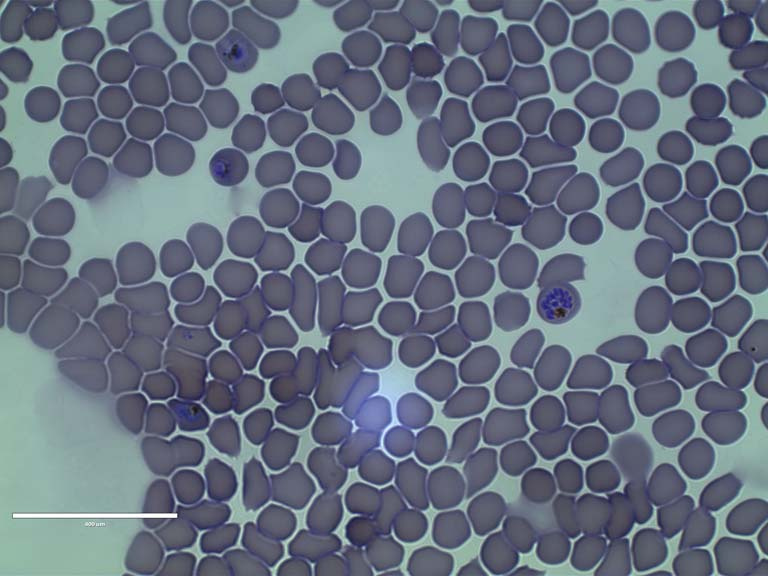

Malaria Parasites Invade Blood Cells 2
Malaria Parasites Invade Blood Cells 2
Dean Glettig, Angela DiCiccio, Veronica Montgomery, Cody Cleveland, Giovanni Traverso, Robert Langer
Koch Institute at MIT, MIT Department of Chemical Engineering
Malaria parasites invade blood cells of a human body. In these cells they can hide from the body's immune system and multiply by digesting the cell. After 48h they have multiplied so much that they cannot fit inside of the cell anymore, causing it to rupture and releasing the new parasites. To complete the cycle, these new parasites then reinvade new blood cells. This image shows a few parasites hiding inside red blood cells, but also a very rare snapshot image of a cell immediately after bursting and releasing new parasites. Additionally, the golden brown specs are clumps of iron that the parasite deposits while digesting the cell. We are tracking the cycles of malaria parasites in order to test the efficacy of anti-malarial drugs, including artemisinin, for which Youyou To won the 2015 Nobel Prize in Medicine.